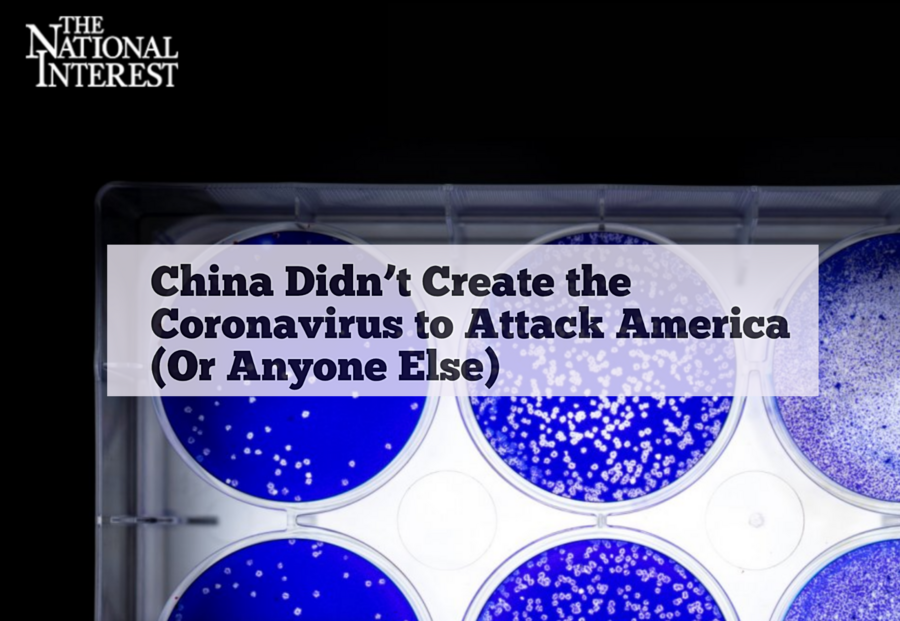

Covid 19 Opinion Piece


Midlands Voices Grand Island Is A Virus Hotspot State Must Push For A Stay Home Policy Opinion Omaha Com
omaha.com

Community Commentary Opinion Nature Connection A Vital Mental Health Resource During The Covid 19 Crisis
www.cvilletomorrow.org

Covid 19 Shows How Precarious The Positions Of Contingent Faculty Actually Are Opinion
www.insidehighered.com

Opinion Piece Covid 19 Highlights Caribbean Community S Need To Build Resilience Ccreee
www.ccreee.org

Transitioning To Virtual Club And Organization Management During Covid 19 Campus Intelligence
www.campusintelligence.com

Opinion The Danger Of Calling The Fight Against Covid 19 A War Opinion Redandblack Com
www.redandblack.com

The Taiwan Example Community Pharmacists Helped Keep Covid 19 Deaths Cases Way Down
www.managedhealthcareexecutive.com

Virtual Becoming The New Normal In The Wake Of Covid 19 Pandemic Opinion Piece By Mahesh Singhi Mergers Alliance
www.mergers-alliance.com

Wellspring Humanities And Arts During Covid 19 Issue One Harts Humanities And Arts Initiative At Pcc
www.pcc.edu